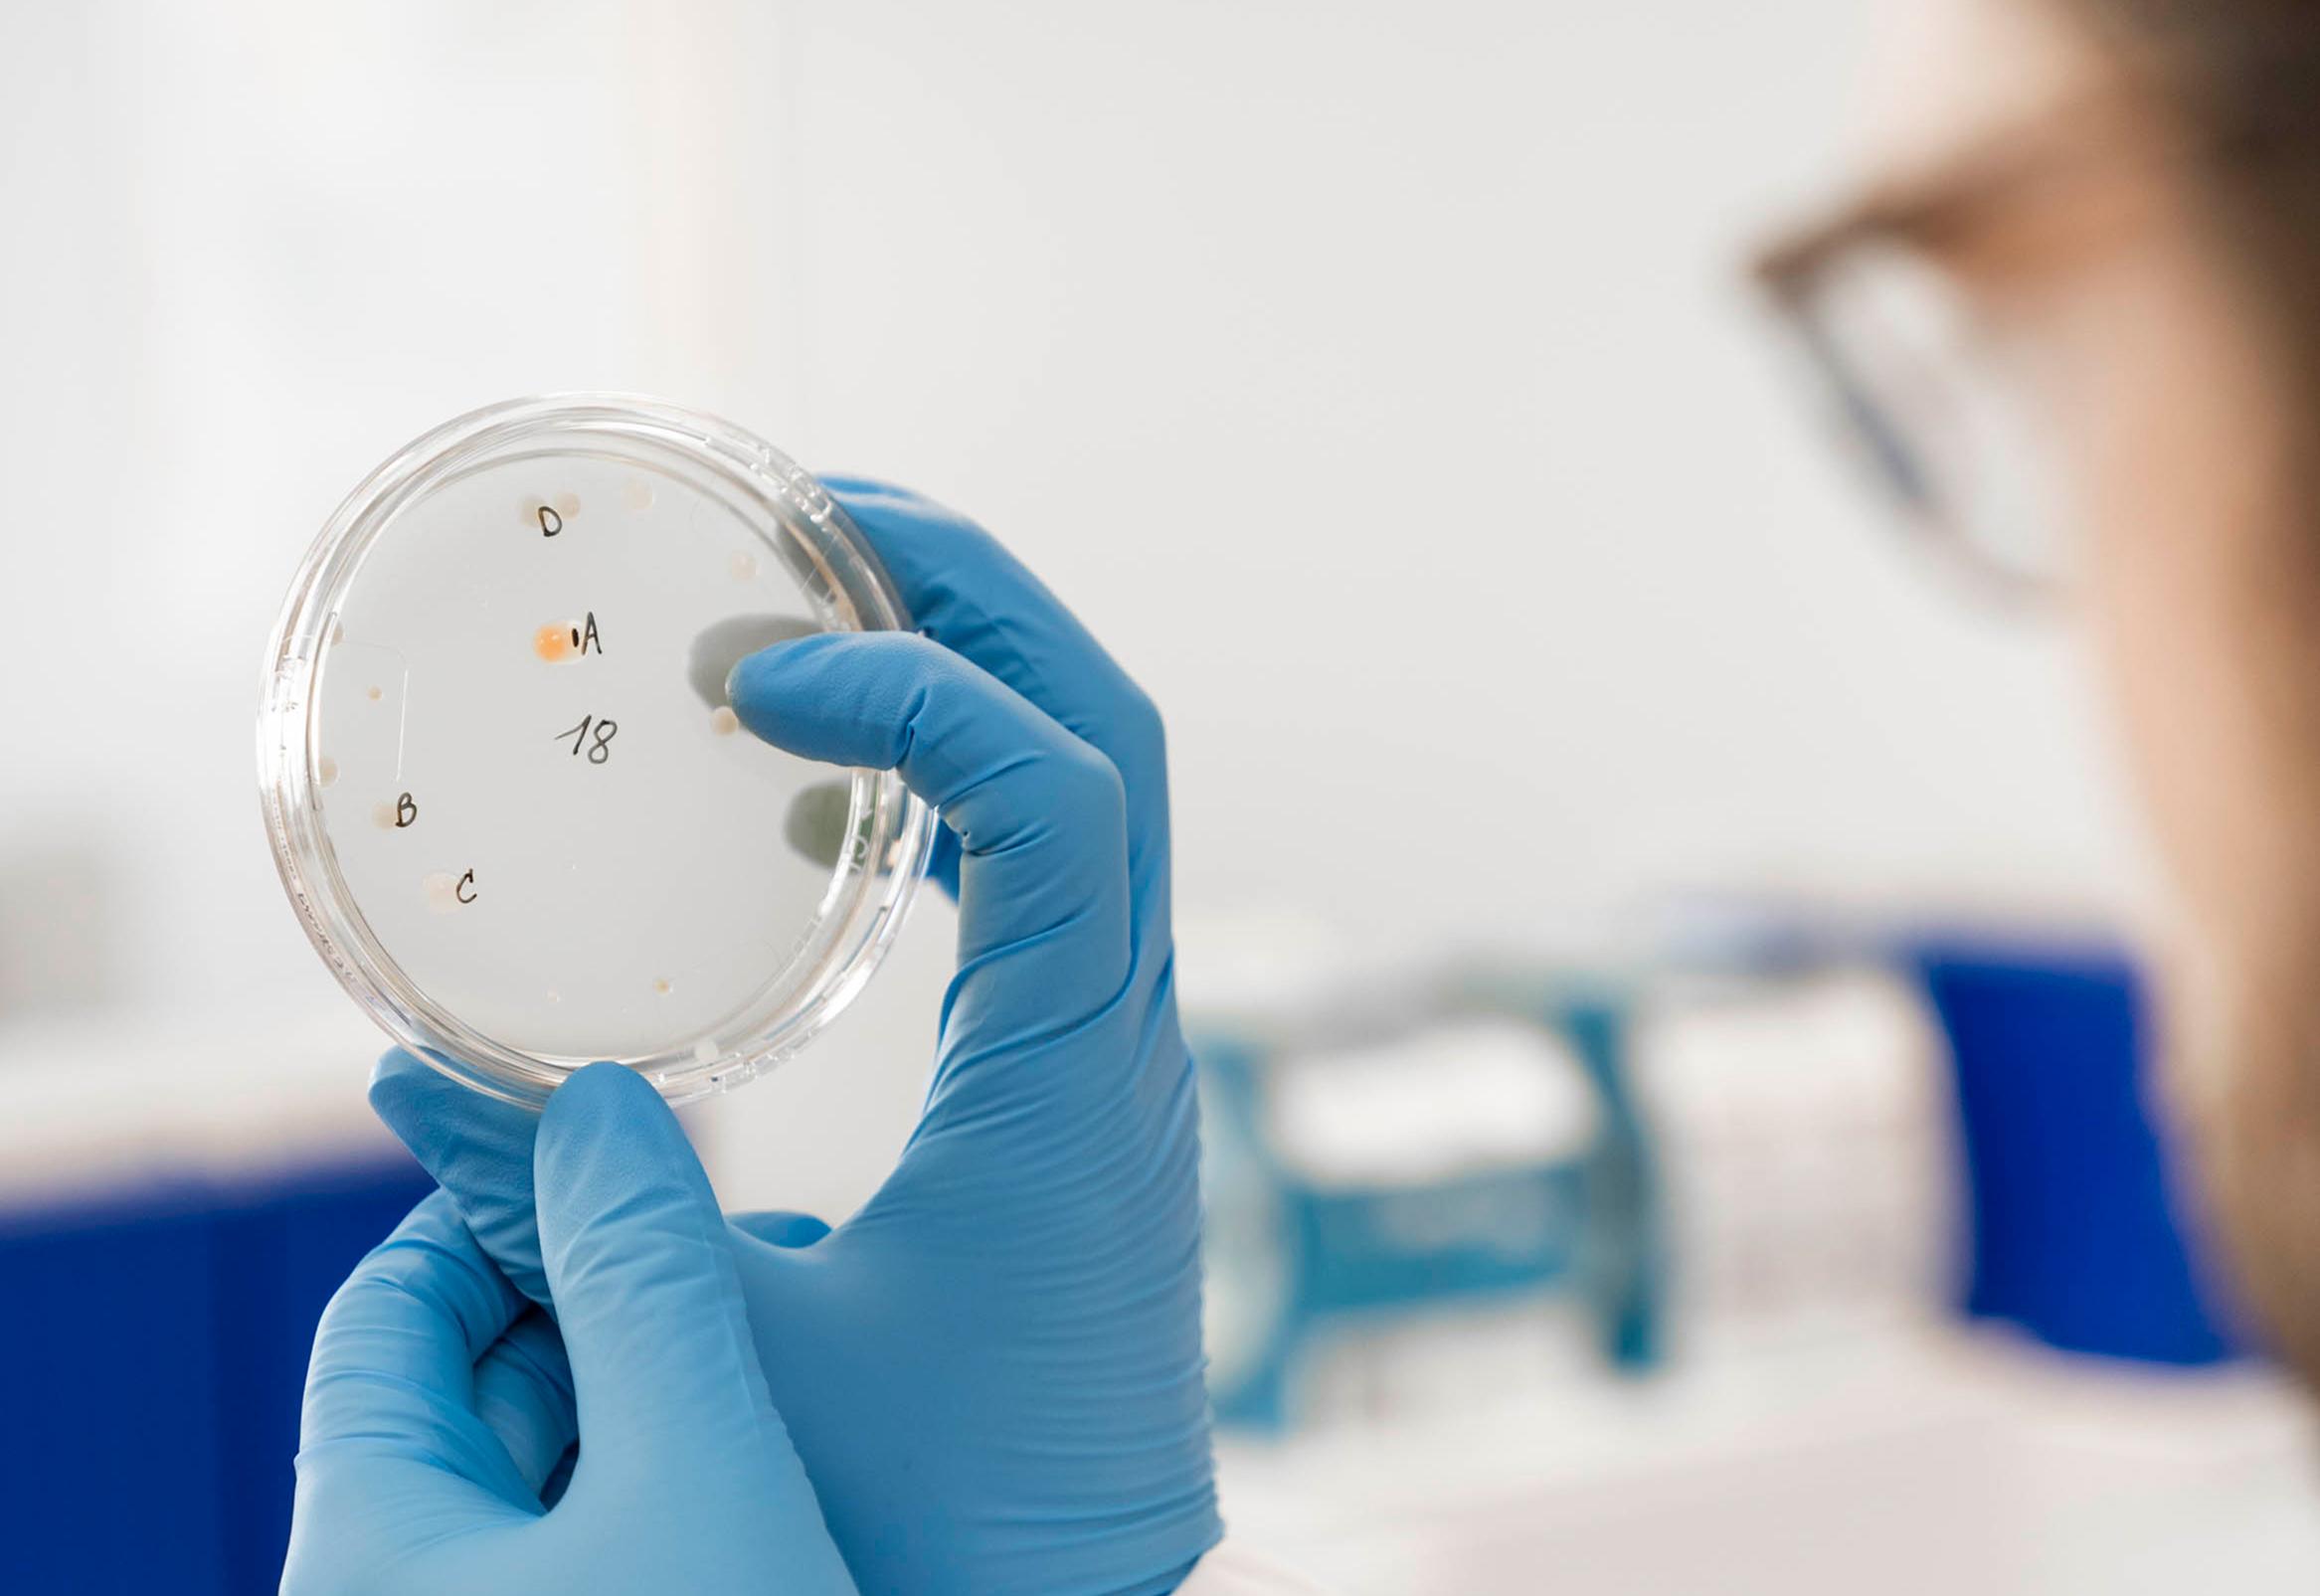

Nieuws
Van skills gap naar skills boost: ViTalent lanceert 5-daags quality bootcamp met de micro-credential ‘Quality in Life Science Production’

De Life Sciences-sector evolueert razendsnel. Nieuwe therapieën, strengere regelgeving en technologische innovaties volgen elkaar in hoog tempo op. Bedrijven hebben daardoor meer dan ooit nood aan goed opgeleide medewerkers die meteen inzetbaar zijn. Toch ervaren veel bedrijven een groeiende skills gap bij startende werknemers: de industrie beweegt sneller dan de curricula!
Van skills gap naar skills boost
ViTalent heeft in het ecosysteem van de Life Sciences een verbindende rol tussen bedrijven en het onderwijs. Met deze micro-credential zetten we dit kracht bij.
In opdracht van de Karel de Grote Hogeschool en samen met experten van verschillende sectorbedrijven ontwikkelden we de module ‘Quality in Life Science Production’ binnen het ‘Advanced Therapies Training Program’ (ATTP) dat bestaat uit verschillende micro-credentials om flexibel in te kunnen spelen op de noden van het werkveld.
In vijf intensieve dagen leren cursisten alle aspecten van kwaliteitszorg in farma en biotech productie kennen. Ze krijgen inzicht in het kwaliteitsproces doorheen de product life cycle: van Critical Quality Attributes tot vrijgave en krijgen principes als Change control, Quality Control, data integriteit, validatie, aseptische technieken en audits in de vingers. Zo bouwen ze competenties op die onmiddellijk inzetbaar zijn op de werkvloer.
Deze ‘Quality in Life Science Production’ overstijgt de ‘Advanced Therapies’ context en is bedoeld voor starters in alle Life Sciences productiebedrijven: drug substance, drug product, biologicals, ATMP, medical devices, enz.
Realistisch leren, echte impact
De opleiding werd ontwikkeld door de trainers van ViTalent, in nauwe samenwerking met experten van de sector. Dat maakt dat de inhoud volledig aansluit bij de realiteit van de industrie. Geen lange theoretische lessen, maar praktijkgerichte sessies, interactieve oefeningen en realistische simulaties in onze GMP-jobsimulator op het Wetenschapspark van de Universiteit Antwerpen in Niel.
Cleanroomgedrag, documentatie en aseptische processen: deelnemers leren het rechtstreeks van experten uit het werkveld. De opbouw van zowel kennis, vaardigheden en attitude maakt dat cursisten na vijf dagen niet alleen begrijpen wat kwaliteit betekent, maar het ook kunnen toepassen in de praktijk.
Volgens Veerle Van der Linden, algemeen directeur van ViTalent, ligt daarin precies de kracht van deze micro-credential:
‘als competentiecentrum hebben wij de opdracht om de skills gap die er is tussen het reguliere onderwijs en de noden binnen de bedrijven van onze sector te dichten. Een zeer efficiënte manier om dit te doen, die de deelnemer bovendien ook nog voorziet van een diploma, is deze micro-credential. Op slechts 5 dagen geraken de cursisten doordrongen van wat kwaliteit in farma en biotech productie exact is. Op de 5de dag wordt hun werk, net zoals dat in de bedrijven ook gaat, ge-audit door een externe auditor.’
Brug tussen onderwijs en industrie
De micro-credential richt zich op startende professionals die hun inwerking willen versnellen of hun rol beter willen begrijpen in het grotere geheel, en op pas afgestudeerden in biomedische laboratoriumtechnologie, (bio)chemie of farmaceutische wetenschappen die zich willen onderscheiden op de arbeidsmarkt.
Ook wie al langer aan de slag is en zich wil om- of bijscholen kan zich inschrijven voor de micro-credentials van het ATTP.
Vanuit het onderwijs klinkt er veel enthousiasme over de samenwerking. Steffi Matthyssen, opleidingshoofd Biomedische Laboratoriumtechnologie aan Karel de Grote Hogeschool, benadrukt het belang van die connectie:
‘In al onze opleidingen hechten wij veel belang aan de connectie met het werkveld. We laten onze studenten kennismaken met het brede ecosysteem waarin zij een meerwaarde kunnen brengen met hun competenties. Deze aanvullende module zoemt specifiek in op de werkomstandigheden van de farma- en biotechproductiebedrijven en is daardoor een waardevolle aanvulling. We kozen er bewust voor om deze module dan ook te laten ontwikkelen en geven door ViTalent zodat de bedrijfsrealiteit er volledig in zit.’
Linus De Witte, Trainer en Vakverantwoordelijke QA bij ViTalent, herkent de skills gap tussen onderwijs en industrie uit eigen ervaring:
‘Na mijn hogeschoolopleidingen heb ik zelf ondervonden dat starten met werken in een GMP productieomgeving toch wel een heel andere mindset vraagt. Deze opleiding kunnen ontwikkelen vanuit mijn kennis van de reguliere opleidingen gecombineerd met mijn bedrijfservaring maakt de cirkel rond.’
Kris Bosch, Advisor Education & Labour Market bij essenscia en voorzitter van ViTalent, licht de steun vanuit de sector toe:
‘We zetten binnen essenscia sterk in op allerlei initiatieven die inspelen op de skills noden van onze bedrijven. Voor de hele sector zijn er zo maar even 4 competentiecentra, waarvan ViTalent zich specifiek inzet voor de Vlaamse farma en biotech bedrijven. Deze micro-credential is een logische volgende stap in de rol die ViTalent opneemt als verbinding tussen bedrijven en onderwijs en ondersteunt de bedrijven in hun efforts rond competentieopbouw. Dankzij de middelen die de sociale partners via het vormingsfonds Co-valent hebben toegekend, kon de vijfdaagse opleiding ontwikkeld worden en is deze nu beschikbaar voor de hele sector.’
De ontwikkeling van deze opleiding werd mede mogelijk gemaakt dankzij de steun vanuit het sectoraal vormingsfonds Co-valent en EFRO (Europees Fonds voor Regionale Ontwikkeling).
Praktisch
De micro-credential ‘Quality in Life Science Production’ duurt vijf dagen, telkens van 8u30 tot 16u30, en wordt gegeven in het Engels bij ViTalent in het wetenschapspark Universiteit Antwerpen te Niel.
De kostprijs bedraagt 1850 euro, inclusief materiaal, lunch en parking. Na succesvolle afronding ontvangen deelnemers een erkend getuigschrift.
De eerste editie start op 23 maart 2026.
Inschrijven kan via de website van Karel de Grote Hogeschool: Quality in Life Science Production

